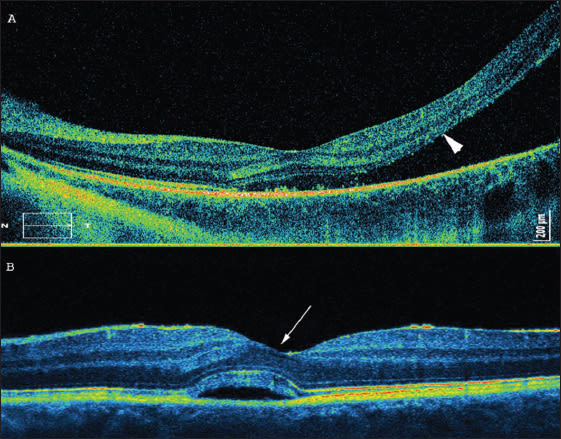

Retinal Regeneration as Illustrated by SD-OCT
Imaging offers clues to the possibility of regeneration in humans
Zofia Michalewska, MD, PhD • Jerzy Nawrocki, MD, PhD
The first remarks on retinal regeneration date back to the 17th century, when Charles Bonnet discovered that newts could regenerate their eyes after surgical removal of small parts.1 Early in the 20th century, regeneration of the lens and retina was the main experimental model for regeneration research.2 As in most mammals, loss of neurons in the human retina does not naturally lead to their replacement. However, several strategies have been described that lead to repair.
Optical coherence tomography has become an important tool in the last decade, as it enabled, for the first time, the visualization of fine retinal structures with details that could be only compared to histological studies. Developments in this technology have lead to increased imaging speed and resolution and brought spectral-domain optical coherence tomography to everyday ophthalmic practice. The possibilities of in vivo visualization of the human eye are awesome.
RETINAL REGENERATION IN ANIMALS
While there are great possibilities for regeneration of the eye in nonvertebrates, the more complicated the ocular tissue the more complicated the regeneration process. Different fish species, for example, have the ability to generate new retinal neurons in adult life and thus to replace damaged retinal cells. In the first days after retina damage, new ganglion cells are produced in fish from pluripotent stem cells, most probably Müller cells. The next step is axon growth, which reconnects retinal tissue to the optic nerve head.3
For many centuries, urodeles have been known for their capability for regeneration of the retina and lens. Despite intense studies, no specific retinal progenitor cell has been found in these animals. Again, Müller cells dedifferentiate and initiate the reparation process.4
In the avian retina, Müller cells may serve as retinal progenitor cells in the first postnatal week, whereas later in life, only peripheral Müller cells have this capability in chicks.5 The avian retina becomes mitotically active two days after chemical destruction of bipolar and amacrine cells. The mitotically active cells have a marker of Müller cells. It has been suggested that Müller cells in chicks may serve as progenitor cells for all retinal neurons.
It has long been believed that the adult mammalian retina is incapable of regeneration. More recently, it was proved that, after injury, Müller glial cells proliferated to produce rod photoreceptors and bipolar cells in the adult rat retina.6 Also, stem cells capable of generating new neurons6,7 are present in the nonpigmented ciliary margin in rodents.8
There are several explanations for retina regeneration in animals. A small zone of mitotically active cells in the adult retina, called the ciliary marginal zone (CMZ), was the first explanation to be offered. This zone consists of cells that resemble retinal progenitor cells. Unlike the CMZ of fish and amphibians, the cells at the margin of the chick retina only generate bipolar and amacrine cells in the undamaged retina, suggesting that the progenitors in the CMZ may be restricted to producing particular neuronal cell types.5 In primates there is lack of evidence of a persistent CMZ after birth.
The second explanation proposed was that an intrinsic progenitor cell, recently identified as Müller glia, which normally produces only rod photoreceptors during the growth of the fish eye, is responsible for regeneration.9,10 Müller glial cells are able to dedifferentiate, and they have the potential to become retinal progenitors.11 They act as intrinsic retinal stem cells that normally have a very long cell cycle and are activated after injury.12,13
Numerous genes are expressed by retinal progenitor cells. Ascl1a was described to be responsible for dedifferentiation of Müller cells into multipotent progenitors.14
HUMAN RETINAL ANATOMY AND PRENATAL DEVELOPMENT
The retina in vertebrates develops from paired optic vesicles, being anterior parts of the neural tube. As soon as optic vesicles form optic cups, retinal progenitor cells are present. They enable differentiation of all types of retinal neurons and Müller glia cells. It has been known since the mid-19th century that retinal neurons differentiate in a specific order from retinal progenitor cells.
Ganglion cells, cone photoreceptors, horizontal cells and most amacrine cells are generated during early stages of development, and rod photoreceptors, bipolar cells and Müller glia are generated in the latter half of the period of retinogenesis.15 Apicolaterally, Müller cells are connected to their neighboring Müller and photoreceptor cells by specialized junctions to form the outer limiting membrane.
SD-OCT demonstrates high-resolution images of the retina (Figure 1), which may resemble histological dissection. Several layers, such as the nerve fiber layer, the junction between the inner and outer segments of photoreceptors, and the retinal pigment epithelium, have a high degree of backscattering, which produces highly reflective bands on SD-OCT images. The inner and outer plexiform layers have slightly more backscattering than the ganglion cell layer and inner and outer nuclear layers; thus, those structures may be differentiated.

Figure 1. Spectral-domain optical coherence tomography of a healthy fovea: NFL: nerve fiber layer; GCL: ganglion cell layer; IPL: inner plexiform layer; INL: inner nuclear layer; OPL: outer plexiform layer; ONL: outer nuclear layer; ELM: external limiting membrane; IS/OS: junction between inner and outer segments of photoreceptors; RPE: retinal pigment epithelium.
Reflections on OCT from the IS/OS are thought to arise from the abrupt change in the optical index of refraction at the boundary between the inner segments and the highly organized structure of the outer segments. To visualize particular retinal layers with SD-OCT, the layer has to be perpendicular to the incoming OCT beam. Thus, the IS/OS is visible in the healthy retina and may be missed in detached tissue (Figure 2a). If, on the other hand, the SD-OCT device is turned a little bit to the side, it is possible to detect the Henle's fiber layer.16 The Henle's fiber layer is also visible if neurosensory retina is detached, as in central serous chorioretinopathy. The Henle's fiber layer forms the outer two-thirds of the outer plexiform layer. Henle's fibers are axonal extensions of photoreceptors, enveloped in lucent outer cytoplasm of the Müller cells, and they run obliquely from the center out to their pedicles (Figure 2b).
Figure 2. Retinal detachment near the fovea. (A, top) The arrow shows the presumed IS/OS line, which is not visible central serous chorioretinopathy. (B, bottom) The arrow shows Henle's fibers.
SD-OCT STUDIES ON RETINAL REGENERATION
Restoration of retinal structure, either spontaneously or following surgical or medical intervention, has been described in many clinical entities. Causes and underlying processes may differ and are presented here.
Macular Hole
Since the introduction of pars plana vitrectomy as the method of choice in full-thickness macular hole treatment, the success rate has reached almost 100%.17-24 However, in some patients, especially with large, longstanding macular holes, incomplete improvement of visual acuity is observed immediately after surgery. This outcome is due to different defects of the particular retinal layers, which can be observed on SD-OCT (Figure 3). IS/OS defects have been reported to have the strongest influence on visual acuity.

Figure 3A (top). SD-OCT one month after macular hole surgery. A hyporeflective area beneath the outer nuclear layers is visible. The junction between the inner and outer segments of photoreceptors (IS/OS) is incomplete. (B, bottom) SD-OCT 12 months after macular hole surgery. Complete restoration of the IS/OS line is observed.
Recently, several authors have analyzed postoperative changes in retinal morphology after macular hole surgery, and it was proved that visual acuity may improve for at least 12 months after surgery.23
Improvement of visual acuity corresponds with improvement of morphology in the outer retinal layers and with restoration of the IS/OS line. Michalewska et al. reported on 71 eyes, among which 93% had photoreceptor defects one week after surgery, and 29.5% had defects 12 months after surgery. The linear photoreceptor defect continuously decreased in size with time (from a mean of 882 µm one week after surgery to 60 µm 12 months after surgery).
Injury has been described as a signal for activation of Müller cells. It is likely that peeling of the internal limiting membrane, which is not a pathological tissue but part of the retinal structure, simulates injury, provoking gliosis.25
It must be remembered that what we see with SD-OCT is not really the photoreceptor layer but the junction between inner and outer segments. If outer segments are damaged, then the line may be defective. Thus, injury may provoke phagocytosis of the damaged cells and production of new outer segments. This process may cause the IS/OS line to reappear.
Another theory is that injury may provoke edema of Müller cells and enlarge the distances between particular photoreceptors. This result would move each photoreceptor slightly to a new position. Such pushing of photoreceptors may also improve the IS/OS line visible on SD-OCT.
Lamellar Macular Hole
Lamellar macular holes appear on SD-OCT examination as non–full-thickness macular holes, coexisting with epiretinal membranes in most cases (Figure 4). Recent SD-OCT studies have proved that IS/OS defects may be present in lamellar macular holes.26,27 Michalewska et al. presented a disruption of the line representing the junction of the inner and outer segments of photoreceptors in 10 of 26 patients qualified for surgery. The mean linear diameter of the defect was 848 µm before surgery. Pars plana vitrectomy with ILM peeling and no tamponade was performed.

Figure 4A. Lamellar macular hole with epiretinal membrane and defect of the junction between inner and outer segments of photoreceptors in the same eye surgery. (B) Restoration of the IS/OS line may be observed.
Interestingly, 12 months after surgery, photoreceptor defects diminished in six eyes, which correlated with improvement of visual acuity. As ILM peeling was performed in all cases in our study, it might have been a signal for retina restoration.
Central Serous Chorioretinopathy
Central serous chorioretinopathy (CSC) usually occurs in young men. The typical SD-OCT appearance is focal serous retinal detachment in the macular area. Most cases of serous choroidal retinopathy resolve spontaneously. However, in some long-lasting cases, laser treatment or PDT with low-dose verteporfin is advised. Decreased visual acuity, besides normalization of the fovea contour in OCT, may be noted, both after spontaneous resolution and after treatment. This result has been reported to be due to persisting defects of the junction between the inner and outer segments of the photoreceptors, as visualized with SD-OCT.28
Ojima et al. examined 74 eyes with resolved CSC using SD-OCT. In 71.6% of cases, the IS/OS line had no defects immediately after resolution of the focal detachment, which corresponded to good visual acuity. Fifteen eyes with defects of the IS/OS were followed up for about 11 months. It was, however, reported that in nine of 15 eyes after resolved CSC, which initially showed disruptions of the IS/OS line, a recovery of this line presented with time.29 In those eyes, visual acuity had a continuous tendency to improve. In the other six of 15 eyes, the defects remained unchanged.
AZOOR Complex
Acute zonal occult outer retinopathy, first described by Gass, is nowadays defined as a group of diseases (AZOOR complex30) with different etiologies but similar clinical appearances, among those: multiple evanescent white dot syndrome, multifocal choroiditis and panuveitis, and acute macular neuroretinopathy. These diseases mostly affect young women and present with visual field loss and photopsias. SD-OCT shows loss of the IS/OS boundary and noticeable focal outer nuclear layer thinning during acute phases of the diseases.
Multiple evanescent white dot syndrome (MEWDS) is a disease of unknown origin, affecting mostly young women. Multiple white spots visible on the fundus, decreased visual acuity, and spontaneous resolution after one or two months are typical. Indocyanine green and fluorescein angiography suggest that the changes are located in the outer retina and RPE. Improvement in visual acuity may correlate with restoration of the IS/OS junction.31,32 It must be noted that, in MEWDS, even if the IS/OS line is defective, the external limiting membrane is present with no defects in all cases. It has been reported that defects in the IS/OS line completely disappear with time.
Sikorski et al. hypothesized that the IS/OS line may be invisible on SD-OCT because photoreceptors are swollen.33 They do not regenerate but become visible when the process is over. Hangai et al. demonstrated that the areas of IS/OS defects correlate with moderate reflective focal lesions and with hypofluorescent lesions on indocyanine green angiography.34
Vogt-Kobayashi-Harada Syndrome
Vogt-Kobayashi-Harada syndrome is a systemic inflammatory disorder in which the autoimmune system is reactive against melanocytes. Spaide et al. reported, however, on regeneration of outer retina viewed with foveal cone densitometry, focal macular electroretinogram, and time-domain OCT.35
Healing of Photocoagulation Lesions
Panfundus photocoagulation is the treatment of choice for proliferative diabetic retinopathy. During photocoagulation, a number of photoreceptors are destroyed; thus, oxygenation of the rest of the retina improves. Side effects include, among others, retinal scarring, which induces scotomas and which may increase with time. Animal studies have been performed to understand the process better.36-38
In rodents, lesion size was found to decrease over time due to migration of photoreceptors from the untreated surrounding areas filling in the damaged outer retina. Lesions of 200 µm showed resolution of damage in the photoreceptor layer, whereas 800 µm lesions did not. This observation suggests that photoreceptor migration/restoration may have a finite limit.39
The process of the repopulation of regions of photoreceptor damage by healthy photoreceptors was described to be associated with actin.40 These results are interesting, but it must be taken into consideration that no retinal scarring is observed in rodents. Histological studies on rabbits seem to be a model more similar to the human eye.
A study using a semiautomated retinal photocoagulation system (Pascal, Topcon Medical) was performed. This system enables the surgeon to control precisely the lesion size and the amount of energy used. One hour after laser was performed, damage was seen in all retinal layers and in the RPE and partially in the choroid, with coexisting tissue edema in moderate and intense lesions. In barely visible lesions, only the outer retina was affected.
One day after treatment, the edema had almost resolved. No matter how intense the laser was, the photoreceptors remained damaged, and pyknotic nuclei were present in the outer nuclear layer. In intense and moderate lesions, pyknotic nuclei were also observed in the inner nuclear layer. The lesion size contracted continuously for about two months and then stayed unchanged for up to half a year after laser. An interesting aspect is that, in intense and moderate lesions, the lesion size contracted to about 40%, but barely visible spots almost completely disappeared. The authors observed that pigmented cells invaded all retinal layers with coexisting gliosis.36 Lateral photoreceptor migration was observed up to four months after laser.
Kriechbaum et al. presented for the first time the in vivo appearance of photocoagulation lesions in SD-OCT in diabetic patients. The laser burns were visualized with SD-OCT after one day, and tissue damage could be observed in the outer retinal layers, beginning with outer plexiform layer. They reported that, one week after photocoagulation, the size of the lesion contracted in comparison to its transversal and longitudinal diameter. The line representing the junction between the inner and outer segments of photoreceptors and another hyper-reflective line representing the RPE unified, forming one hyper-reflective structure.
In the first three weeks following laser injury, the defect of the IS/OS line enlarged slightly. However, it was noted that outer nuclear layer partially recovered. It must be noted, though, that the ONL remained thinned a little bit three to six months after laser burns were performed, and the photoreceptor layer defect was not observed to have changed.41
The same group analyzed SD-OCT after grid laser photocoagulation in diabetic macular edema. One day after the laser burns were performed, there was damage to the photoreceptor layer, RPE and, to some extent, to the outer nuclear layer. It seems interesting but further studies of how the lesions would change with time are required.42
To conclude, after laser application, some extent of photoreceptor migration and recovery of the destructed photoreceptor layer were observed in rodents and rabbits, but in vivo SD-OCT studies did not confirm that result for humans. Taking into consideration that the primary endpoint of photocoagulation is the destruction of photoreceptors to increase retinal oxygenation, no restoration of photoreceptors following laser-induced injury can explain why this technique is so successful for most patients.
Solar Retinopathy
Solar retinopathy occurs due to looking straight into the sun, sometimes accidentally, but most frequently during a solar eclipse or with “sun gazers,” who look directly into the sun because of religious reasons. The retinal image of the sun in zenith is about 160 mm, which is about 20% of the total macular area. If the pupil is in miosis at about 3 mm, sun watching elevates retinal temperature about 40°C, whereas to photocoagulate retinal tissue 100-200°C is needed. Thus, short-term sun-watching causes a chemical response and not the burning of tissue.43
If the pupil is dilated, exposure is prolonged; if enlarging glasses are used, photocoagulation is possible. Bechman et al. were the first to report hyporeflective areas on TD-OCT in the region of the IS/OS and RPE observed 48 hours after exposure, which disappeared nine days later.44
Defects can be seen on SD-OCT in the photoreceptor layer in solar retinopathy that correspond to microperimetric changes. It was reported that those changes may partly or completely disappear at least six months after exposure.45
CONCLUSIONS
Partial or complete restoration (Figure 5) of defects in the line representing the junction of the inner and outer segments of photoreceptors has been described in a wide range of diseases. Various explanations may be appropriate for these findings.

Figure 5. The same eye as shown in Figure 2A after scleral buckling surgery. A res toration of the line representing the junction of inner and outer segments of photoreceptors is visible.
Some hypotheses suggest that the observed phenomenon is only a masquerade of regeneration. It had already been suggested that the hyper-reflective IS/OS line appears due to back-reflection of the perpendicular photoreceptor stack. If the photoreceptors are not perpendicular to the reflectance beam, they may not be clearly visible. It may also be true that if photoreceptors are detached or are not ideally regular, then the light is not ideally back-scattered, and the IS/OS line may not be seen on SD-OCT.
Another hypothesis is that swollen photoreceptors may not be visible with SD-OCT. If the swelling abates, the photoreceptors become visible again. A further hypotheses is based on the idea of partial regeneration.
It must be remembered that the hyper-reflective line described as the photoreceptor layer is, in reality, the junction between the inner and outer segments of photoreceptors. The outer segments are continuously phagocytized and produced throughout life. If damage affects only the outer segments of photoreceptors, without destruction of the photoreceptor body, then the line probably becomes invisible. After restoration of the outer segments of photoreceptors, the line probably becomes visible again.
After surgical removal of the ILM, Müller cells begin to swell. That swelling may then move photoreceptors to new places. Pulling those particular photoreceptors a little bit apart might look like restoration of the IS/OS line.
However, retinal regeneration was proved to be possible in mammals in experimental studies. SD-OCT images presenting restoration of the IS/OS line often correlate with visual recovery, thus some extent of retinal regeneration should also be considered. Future studies may explain the phenomenon.
It must be considered that, in eyes without RPE damage, restoration of the IS/OS line may be possible, and improvement of visual acuity may continue over many months. RP
REFERENCES
1. Morgan, TH. Regeneration. New York, NY; Columbia University Press;1901.
2. Stone L. The role of retinal pigment cells in regenerating neural retinae of adult salamander eyes. J Exp Zool. 1950;113:9-31.
3. Sherpa T, Fimbel SM, Mallory DE, et al. Ganglion cell regeneration following whole-retina destruction in zebrafish. Dev Neurobiol. 2008 1;68:166-181.
4. Mitashov VI. Mechanisms of retina regeneration in urodeles. Int J Dev Biol. 1996;40:833-44.
5. Fischer AJ, Reh TA. Muller glia are a potential source of neural regeneration in the postnatal chicken retina. Nat. Neurosci. 2001;4:247-252.
6. Ooto S, Akagi T, Kageyama R, et al. Potential for neural regeneration after neurotoxic injury in the adult mammalian retina. Proc Natl Acad Sci U S A. 2004;101:13654-13659.
7. Ahmad I, Tang L, Pham H. Identification of neural progenitors in the adult mammalian eye. Biochem Biophys Res Commun. 2000;270:517-521.
8. Tropepe V, Coles BL, Chiasson BJ, et al. Retinal stem cells in the adult mammalian eye. Science. 2000;287:2032-2036.
9. Raymond PA, Reifler MJ, Rivlin PK. Regeneration of goldfish retina: rod precursors are a likely source of regenerated cells. J Neurobiol. 1988;19:431-463.
10. Bernardos RL, Barthel LK, Meyer JR, Raymond PA. Late-stage neuronal progenitors in the retina are radial Muller glia that function as retinal stem cells. J Neurosci. 2007;27:7028-7040.
11. Raymond PA, Hitchcock PF. Retinal regeneration: common principles but a diversity of mechanisms. Adv Neurol. 1997;72:171-184.
12. Julian D, Ennis K, Korenbrot JI. Birth and fate of proliferative cells in the inner nuclear layer of the mature fish retina. J CompNeurol. 1998;394:271-282.
13. Otteson DC, D'Costa AR, Hitchcock PF. Putative stem cells and the lineage of rod photoreceptors in the mature retina of the goldfish. Dev Biol. 2001;232:62-76.
14. Fausett BV, Goldman D. A role for alpha1 tubulin-expressing Müller glia in regeneration of the injured zebrafish retina. J Neurosci. 2006;26:6303-6313.
15. Sidman, RL. Histogenesis of the mouse retina. Studies with [3H] thymidine. in: The Structure of the Eye. New York, NY; Academic Press; 1961.
16. Otani T, Yamaguchi Y, Kishi S. Improved visualization of Henle fiber layer by changing the measurement beam angle on optical coherence tomography. Retina. 2011;31:497-501.
17. Sano M, Shimoda Y, Hashimoto H, Kishi S. Restored photoreceptor outer segment and visual recovery after macular hole closure. Am J Ophthalmol. 2009;147:313-318.
18. Chang LK, Koizumi H, Spaide RF. Disruption of the photoreceptor inner segment–outer segment junction in eyes with macular holes. Retina. 2008;28: 969-975.
19. Ko TH, Fujimoto JG, Duker JS, et al. Comparison of ultrahighand standard-resolution optical coherence tomography for imaging macular hole pathology and repair. Ophthalmology. 2004;111:2033-2043.
20. Michalewska Z, Michalewski J, Cisiecki S, Adelman R, Nawrocki J. Correlation between foveal structure and visual outcome following macular hole surgery: a spectral optical coherence tomography study. Graefes Arch Clin Exp Ophthalmol. 2008;246:823-830.
21. Michalewska Z, Michalewski J, Cisiecki S, Adelman R, Nawrocki J. Correlation between foveal structure and visual outcome following macular hole surgery: a spectral optical coherence tomography study. Graefes Arch Clin Exp Ophthalmol. 2008;246:823-830.
22. Michalewska Z, Michalewski J, Adelman RA, Nawrocki J. Inverted internal limiting membrane (ILM) flap technique for large macular hole. Ophthalmology. 2010;117:2018-2025.
23. Michalewska Z, Michalewski J, Nawrocki J. Continuous changes in macular morphology after macular hole closure visualized with spectral optical coherence tomography. Graefes Arch Clin Exp Ophthalmol. 2010;248:1249-1255.
24. Lee JE, Lee SU, Jea SY, Choi HY, Oum BS. Reorganization of photoreceptor layer on optical coherence tomography concurrent with visual improvement after macular hole surgery. Korean J Ophthalmol. 2008;22:137-142.
25. Ducournau D, Ducournau Y. A closer look at the ILM. Removal of the ILM induces a cellular response that allows the retina to fight against edema. Retinal Physician. 2008(Suppl 6):4-15.
26. Michalewska Z, Michalewski J, Odrobina D, et al. Surgical treatment of lamellar macular holes. Graefes Arch Clin Exp Ophthalmol. 2010;248:1401-1406.
27. Michalewska Z, Michalewski J, Odrobina D, Nawrocki J. Non-full-thickness macular holes reassessed with spectral domain optical coherence tomography. Retina. 2011 [accepted for publication]
28. Fujimoto H, Gomi F, Wakabayashi T, et al. Morphologic changes in acute central serous chorioretinopathy evaluated by Fourier domain optical coherence tomography. Ophthalmology. 2008;115:1494-1500.
29. Ojima Y, Tsujikawa A, Yamashiro K, Ooto S, Tamura H, Yoshimura N. Restoration of outer segments of foveal photoreceptors after resolution of central serous. Jpn J Ophthalmol. 2010;54:55-60.
30. Spaide RF, Koizumi H, Freund KB. Photoreceptor outer segment abnormalities as a cause of blind spot enlargement in acute zonal occult outer retinopathy-complex diseases. Am J Ophthalmol. 2008;146:111-120.
31. Kanis MJ, van Norren D. Integrity of foveal cones in multiple evanescent white dot syndrome assessed with OCT and foveal refl ection analyser. Br J Ophthalmol. 2006;90:795-796.
32. Spaide RF, Koizumi H, Freund KB. Photoreceptor outer segment abnormalities as a cause of blind spot enlargement in acute zonal occult outer retinopathy-complex diseases. Am J Ophthalmol. 2008;146:111-120.
33. Sikorski BL, Wojtkowski M, Kaluzny JJ, et al. Correlation of spectral optical coherence tomography with fl uorescein and indocyanine green angiography in multiple evanescent white dot syndrome. Br J Ophthalmol. 2008;92:1552-1557.
34. Hangai M, Fujimoto M, Yoshimura N. Features and function of multiple evanescent white dot syndrome. Arch Ophthalmol. 2009;127:1307-1313.
35. Okamoto Y, Miyake Y, Horio N, Takakuwa H, Yamamoto E, Terasaki H. Delayed regeneration of foveal cone photopigments in Vogt-Koyanagi-Harada disease at the convalescent stage. Invest Ophthalmol Vis Sci.. 2004;45:318-322.
36. Paulus YM, Jain A, Gariano RF, et al. Healing of retinal photocoagulation lesions. Invest Ophthalmol Vis Sci. 2008;49:5540-5545.
37. Tackenberg MA, Tucker BA, Swift JS, et al. Müller cell activation, proliferation and migration following laser injury. Mol Vis. 2009;15:1886-1896.
38. Lewis GP, Chapin EA, Luna G, Linberg KA, Fisher SK. The fate of Müller's glia following experimental retinal detachment: nuclear migration, cell division, and subretinal glial scar formation. Mol Vis. 2010;16:1361-1372.
39. Busch EM, Gorgels TG, Van Norren D. Filling-in after focal loss of photoreceptors in rat retina. Exp Eye Res. 1999;68:485-492.
40. Zwick H, Edsall P, Stuck BE, et al. Laser Induced photoreceptor damage and recovery in the high numerical aperture eye of the garter snake. Vision Res. 2008;48:486-493.
41. Kriechbaum K, Bolz M, Deak GG, Prager S, Scholda C, Schmidt-Erfurth U. High-resolution imaging of the human retina in vivo after scatter photocoagulation treatment using a semiautomated laser system. Ophthalmology. 2010;117:545-551. Epub 2010 Jan 19.
42. Bolz M, Kriechbaum K, Simader C, et al.; Diabetic Retinopathy Research Group Vienna. In vivo retinal morphology after grid laser treatment in diabetic macular edema. 2010;117:538-544.
43. Mainster MA. Solar eclipse safety. Ophthalmology. 1998;105:9-10.
44. Bechmann M, Ehrt O, Thiel MJ, Kristin N, Ulbig MW, Kampik A. Optical coherence tomography findings in early solar retinopathy. Br J Ophthalmol. 2000;84:547-548.
45. Ehrt O, Tavcar I, Eckl-Titz G. Microperimetry and reading saccades in retinopathia solaris. Follow-up with the scanning laser ophthalmoscope. Ophthalmologe. 1999;96:325-331.
| Jerzy Nawrocki, MD, PhD, and Zofia Michalewska, MD, PhD, both practice at the Ophthalmic Clinic “Jasne Blonia” in Lodz, Poland. The authors report no financial interest in any product mentioned in this article. Dr. Michalewska may be reached via e-mail at zosia_n@yahoo.com. |








